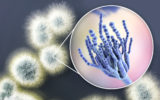

28 октября
-
10:10
Многоразовая ракета работает благодаря ньютоновской физике и старому зонтику
 Новости
Новости
-
9:59
Комета-вулкан извергается активнее, чем за последние 40 лет и стала ярче в 250 раз
 Новости
Новости
-
9:57
Затопленные «корабли-призраки» поднялись со дна Тихого океана после извержения вулкана
 Новости
Новости
27 октября
-
17:09
Раскрыт секрет прочности краски, которую использовали предки инков для «воскрешения» мертвых
 Наука
Наука
-
16:31
Посмотрите на место, где активно рождаются звезды. Оно похоже на Годзиллу
 Наука
Наука
-
15:14
Скрытые у всех на виду: ученые нашли 500 неизвестных храмов майя
 Наука
Наука
-
14:36
Подводные дроны будут ориентироваться в мутной воде как тропические рыбы
 Новости
Новости
-
13:53
Число зараженных птичьим гриппом выросло в 5 раз: возможно, это новый штамм вируса
 Наука
Наука
-
13:30
Ошибка при испытании вакцины помогла ученым понять, как лучше прививаться от COVID-19
 COVID-19
COVID-19
26 октября
-
22:03
Загадочному сигналу с Проксимы Центавра нашли объяснение
 Наука
Наука
-
16:10
Находка ученых раскрыла прошлое Антарктиды в эпоху динозавров
 Наука
Наука
-
15:53
Опубликован первый снимок со 108-мегапиксельной камеры смартфона Xiaomi
 Новости
Новости
-
14:40
Мемы за полмиллиона долларов: кто и зачем продает их на рынке NFT
 Кейсы
Кейсы
-
14:13
Астрономы рассказали, где и как во Вселенной образуются золото и платина
 Наука
Наука
-
13:15
Опасный гриб уже стер с лица Земли земноводных: теперь под угрозой новые виды
Наука
Наука
25 октября
-
19:21
Ученые придумали новый план по уничтожению астероидов: как он работает и не опасно ли это
 Кейсы
Кейсы
-
18:31
Биологи случайно сфотографировали гигантского кальмара и затонувший корабль
 Наука
Наука
-
17:43
Уникальная умная повязка отправляет данные о состоянии раны прямо на смартфон
 Наука
Наука
-
16:58
Испанский вулкан снова ожил: через щели в кратере просачивается лава и угрожает людям
 Новости
Новости
-
12:27
Летающие автомобили появятся раньше, чем ожидалось: уже известна их цена
 Новости
Новости